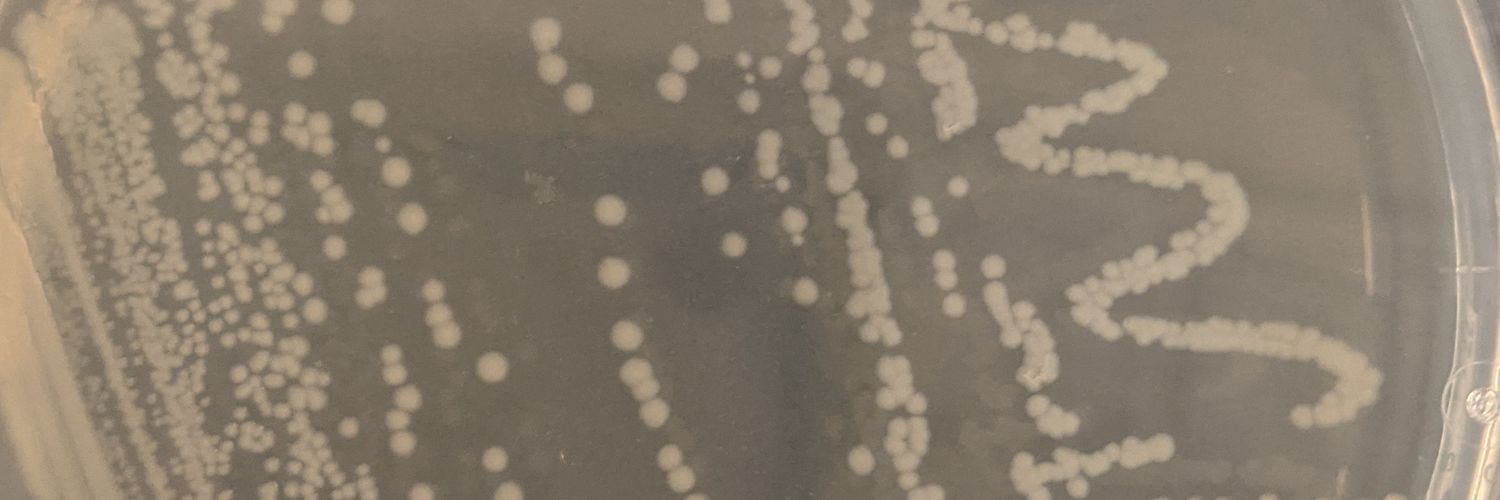
Amanda C. Smith (Shurzinske), PhD banner

Amanda C. Smith (Shurzinske), PhD
191 posts


Amanda C. Smith (Shurzinske), PhD
@ScienceShurz
Biologist studying bacterial STIs
Katılım Mart 2019
172 Takip Edilen52 Takipçiler
Henüz tweet yok
Amanda C. Smith (Shurzinske), PhD
191 posts

@ScienceShurz
Biologist studying bacterial STIs
Henüz tweet yok